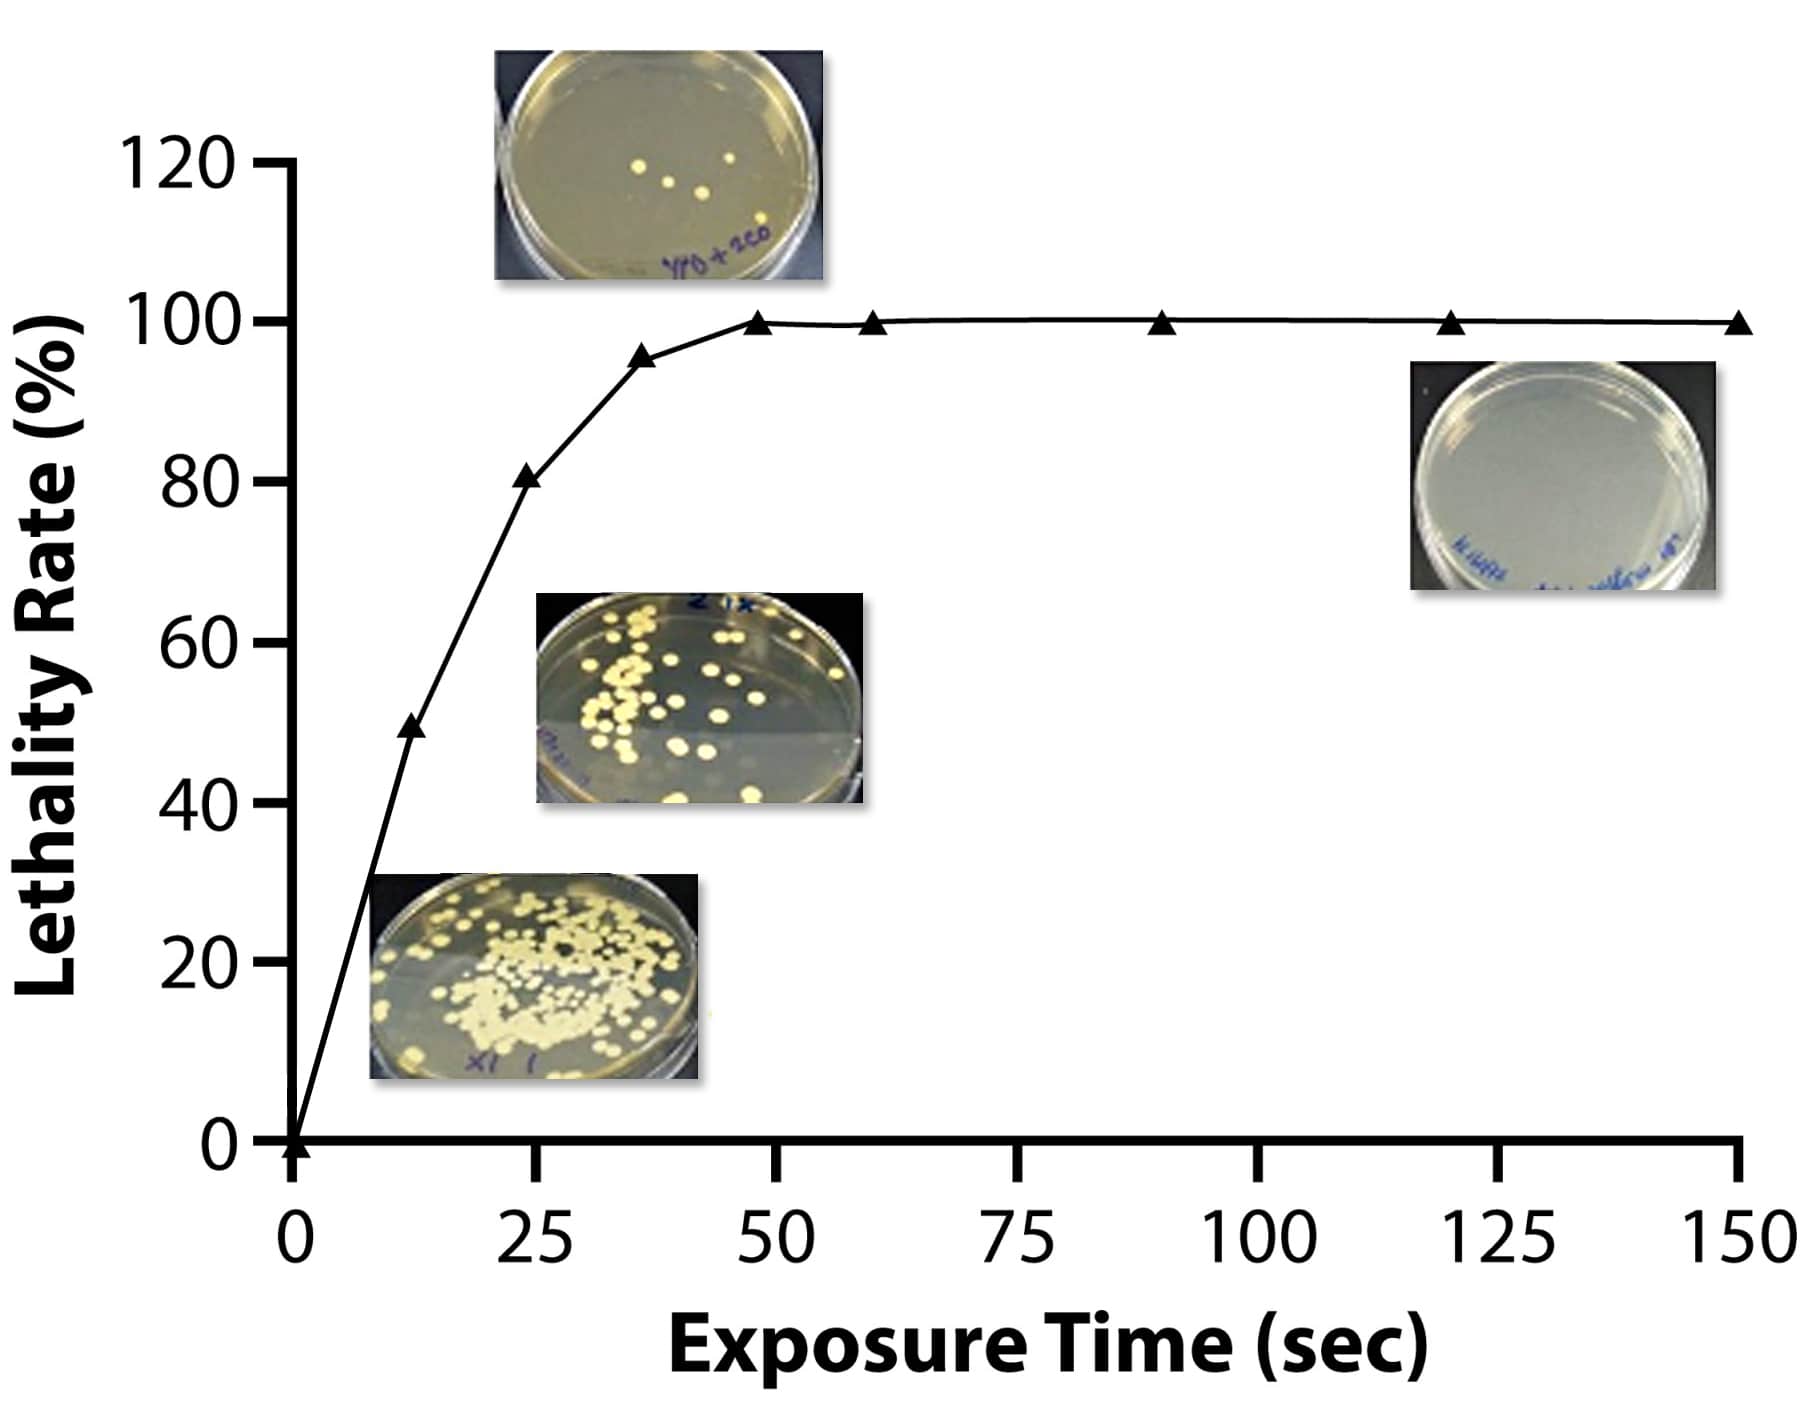
Lethality Rate of Exposed Strains of Microbial Cells at Different Exposure Time

Our Advantage
Utilizing Atmospheric Room Temperature Plasma (ARTP) technology which uses low-pressure plasma to randomly mutate the bases in DNA offers the advantage of high mutation rates, shorter processing time and environmental friendliness compared to other mutagenesis approaches like UV light, α-rays, β-rays, γ-rays, X-rays and chemical mutagenesis.
On the other hand, the Microbial Microdroplet Culture (MMC) system is designed to rapidly screen thousands of strains to identify the optimal production strain with improved phenotypes.